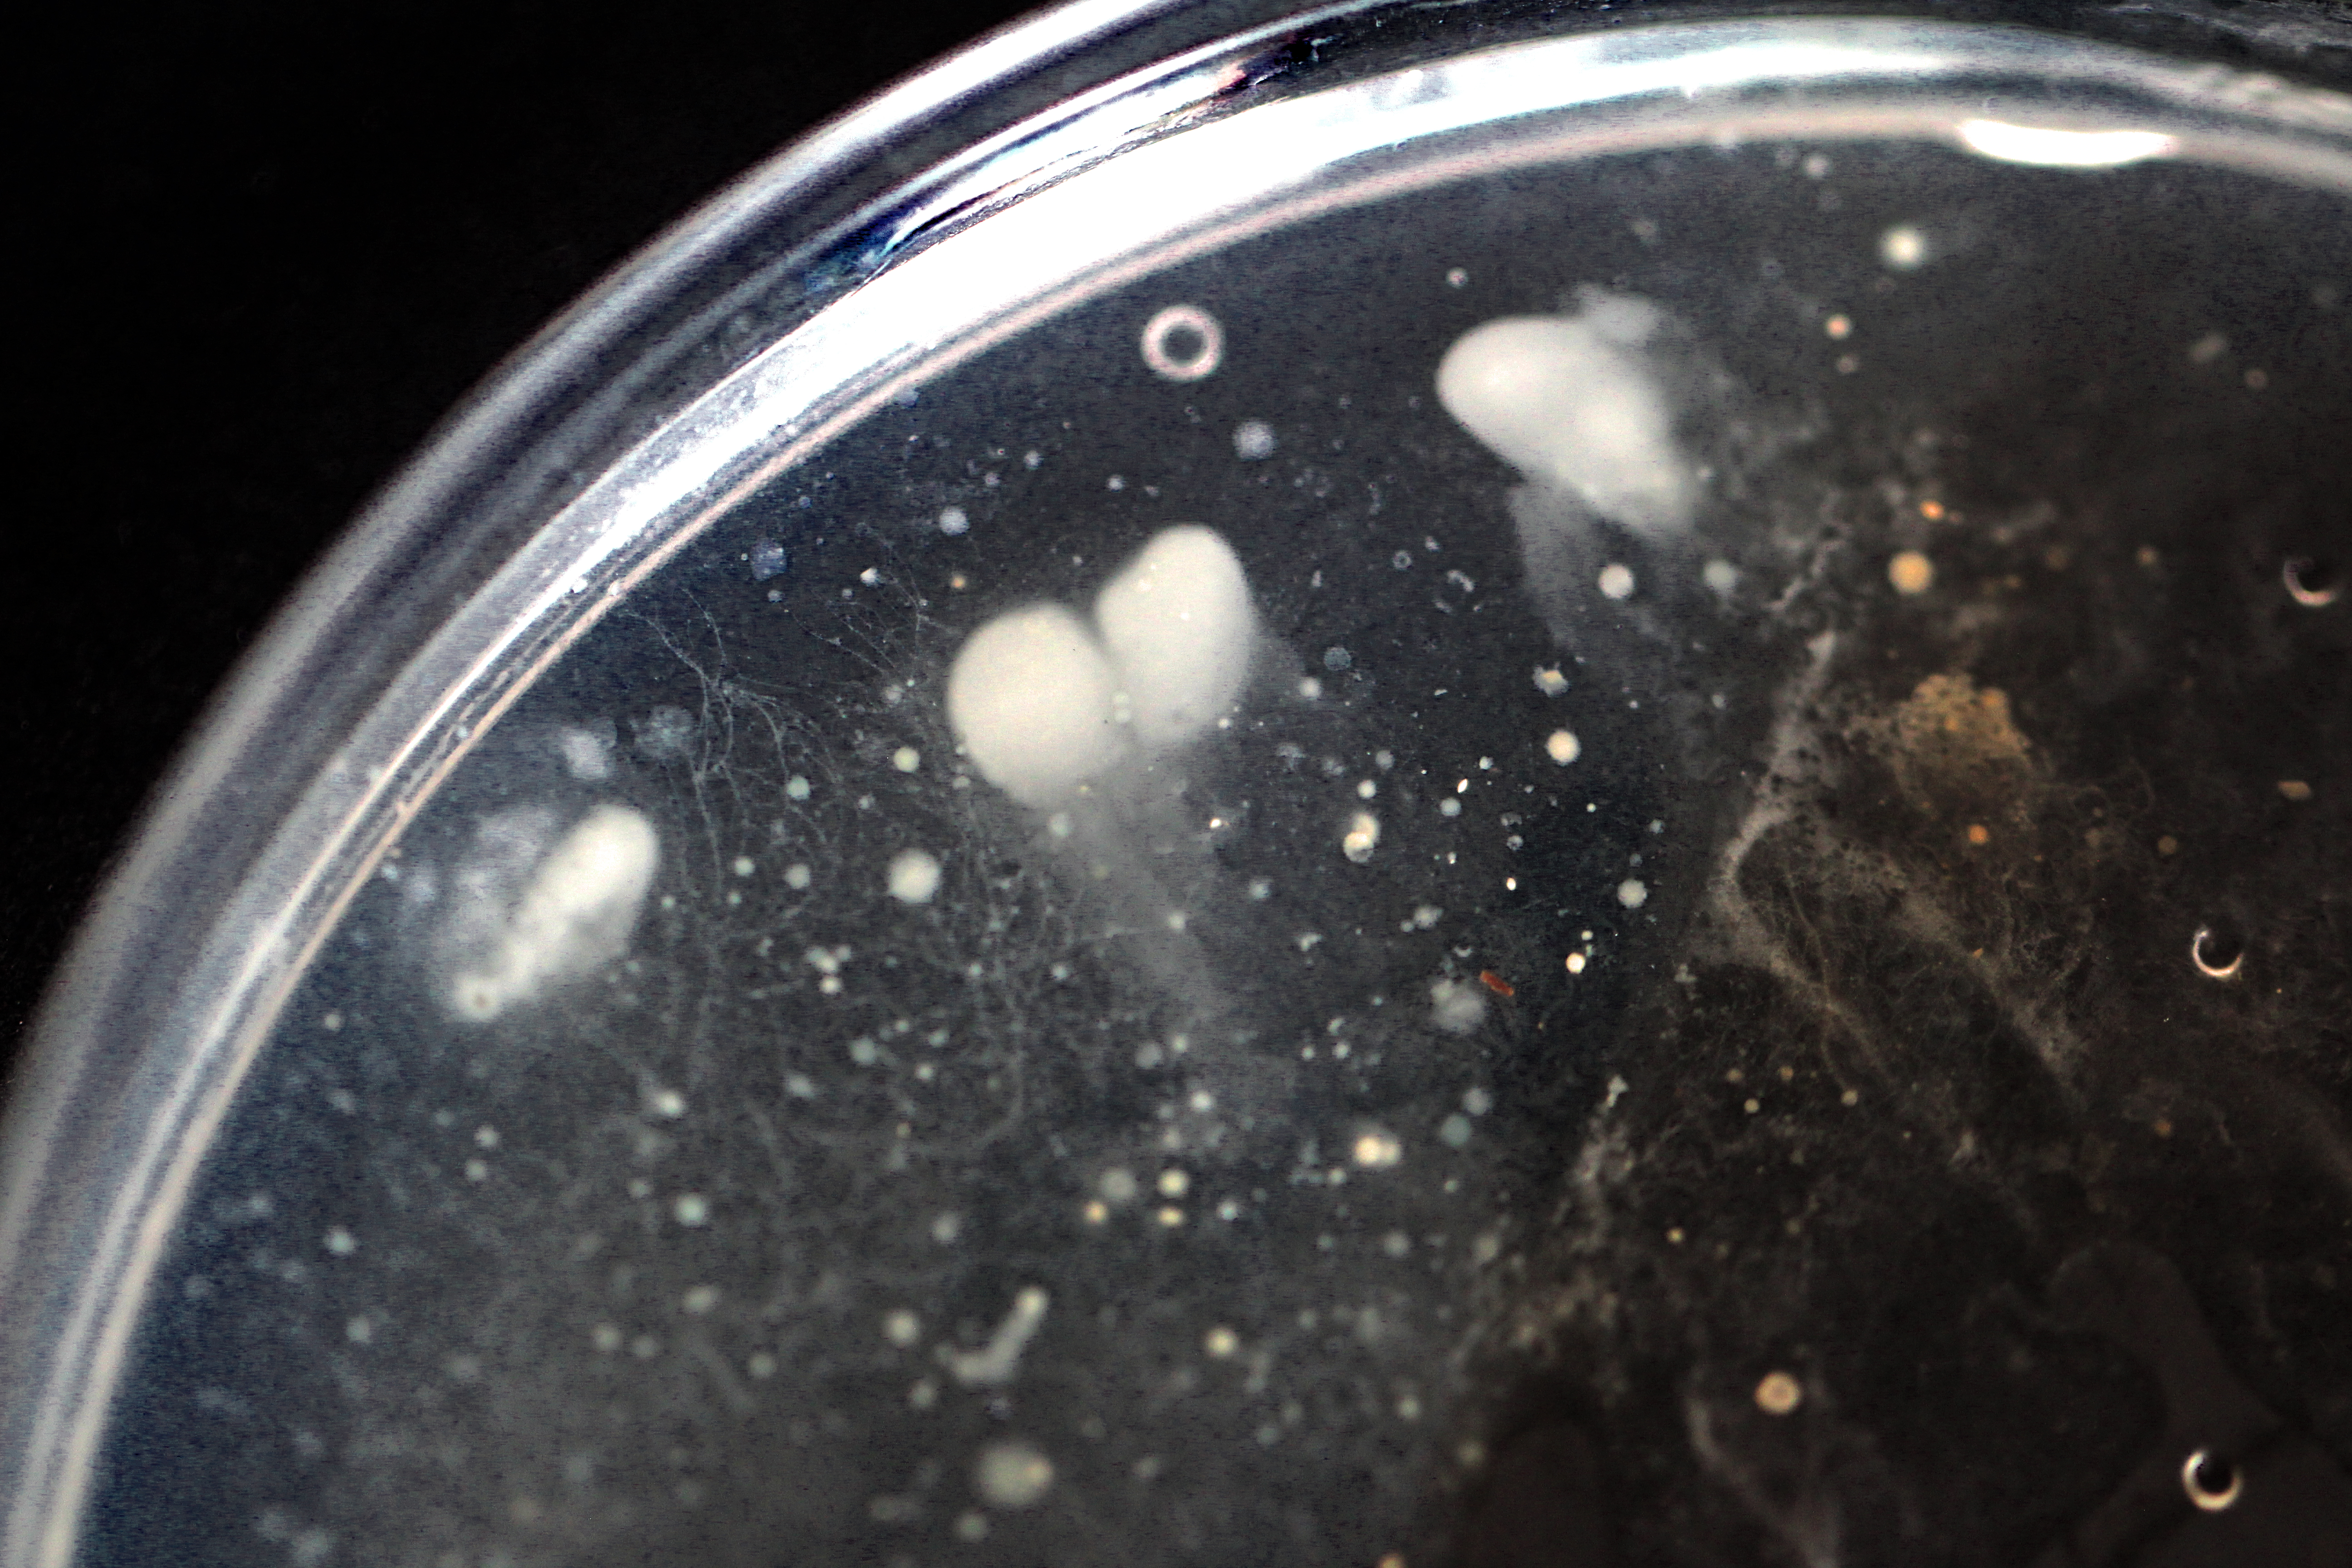
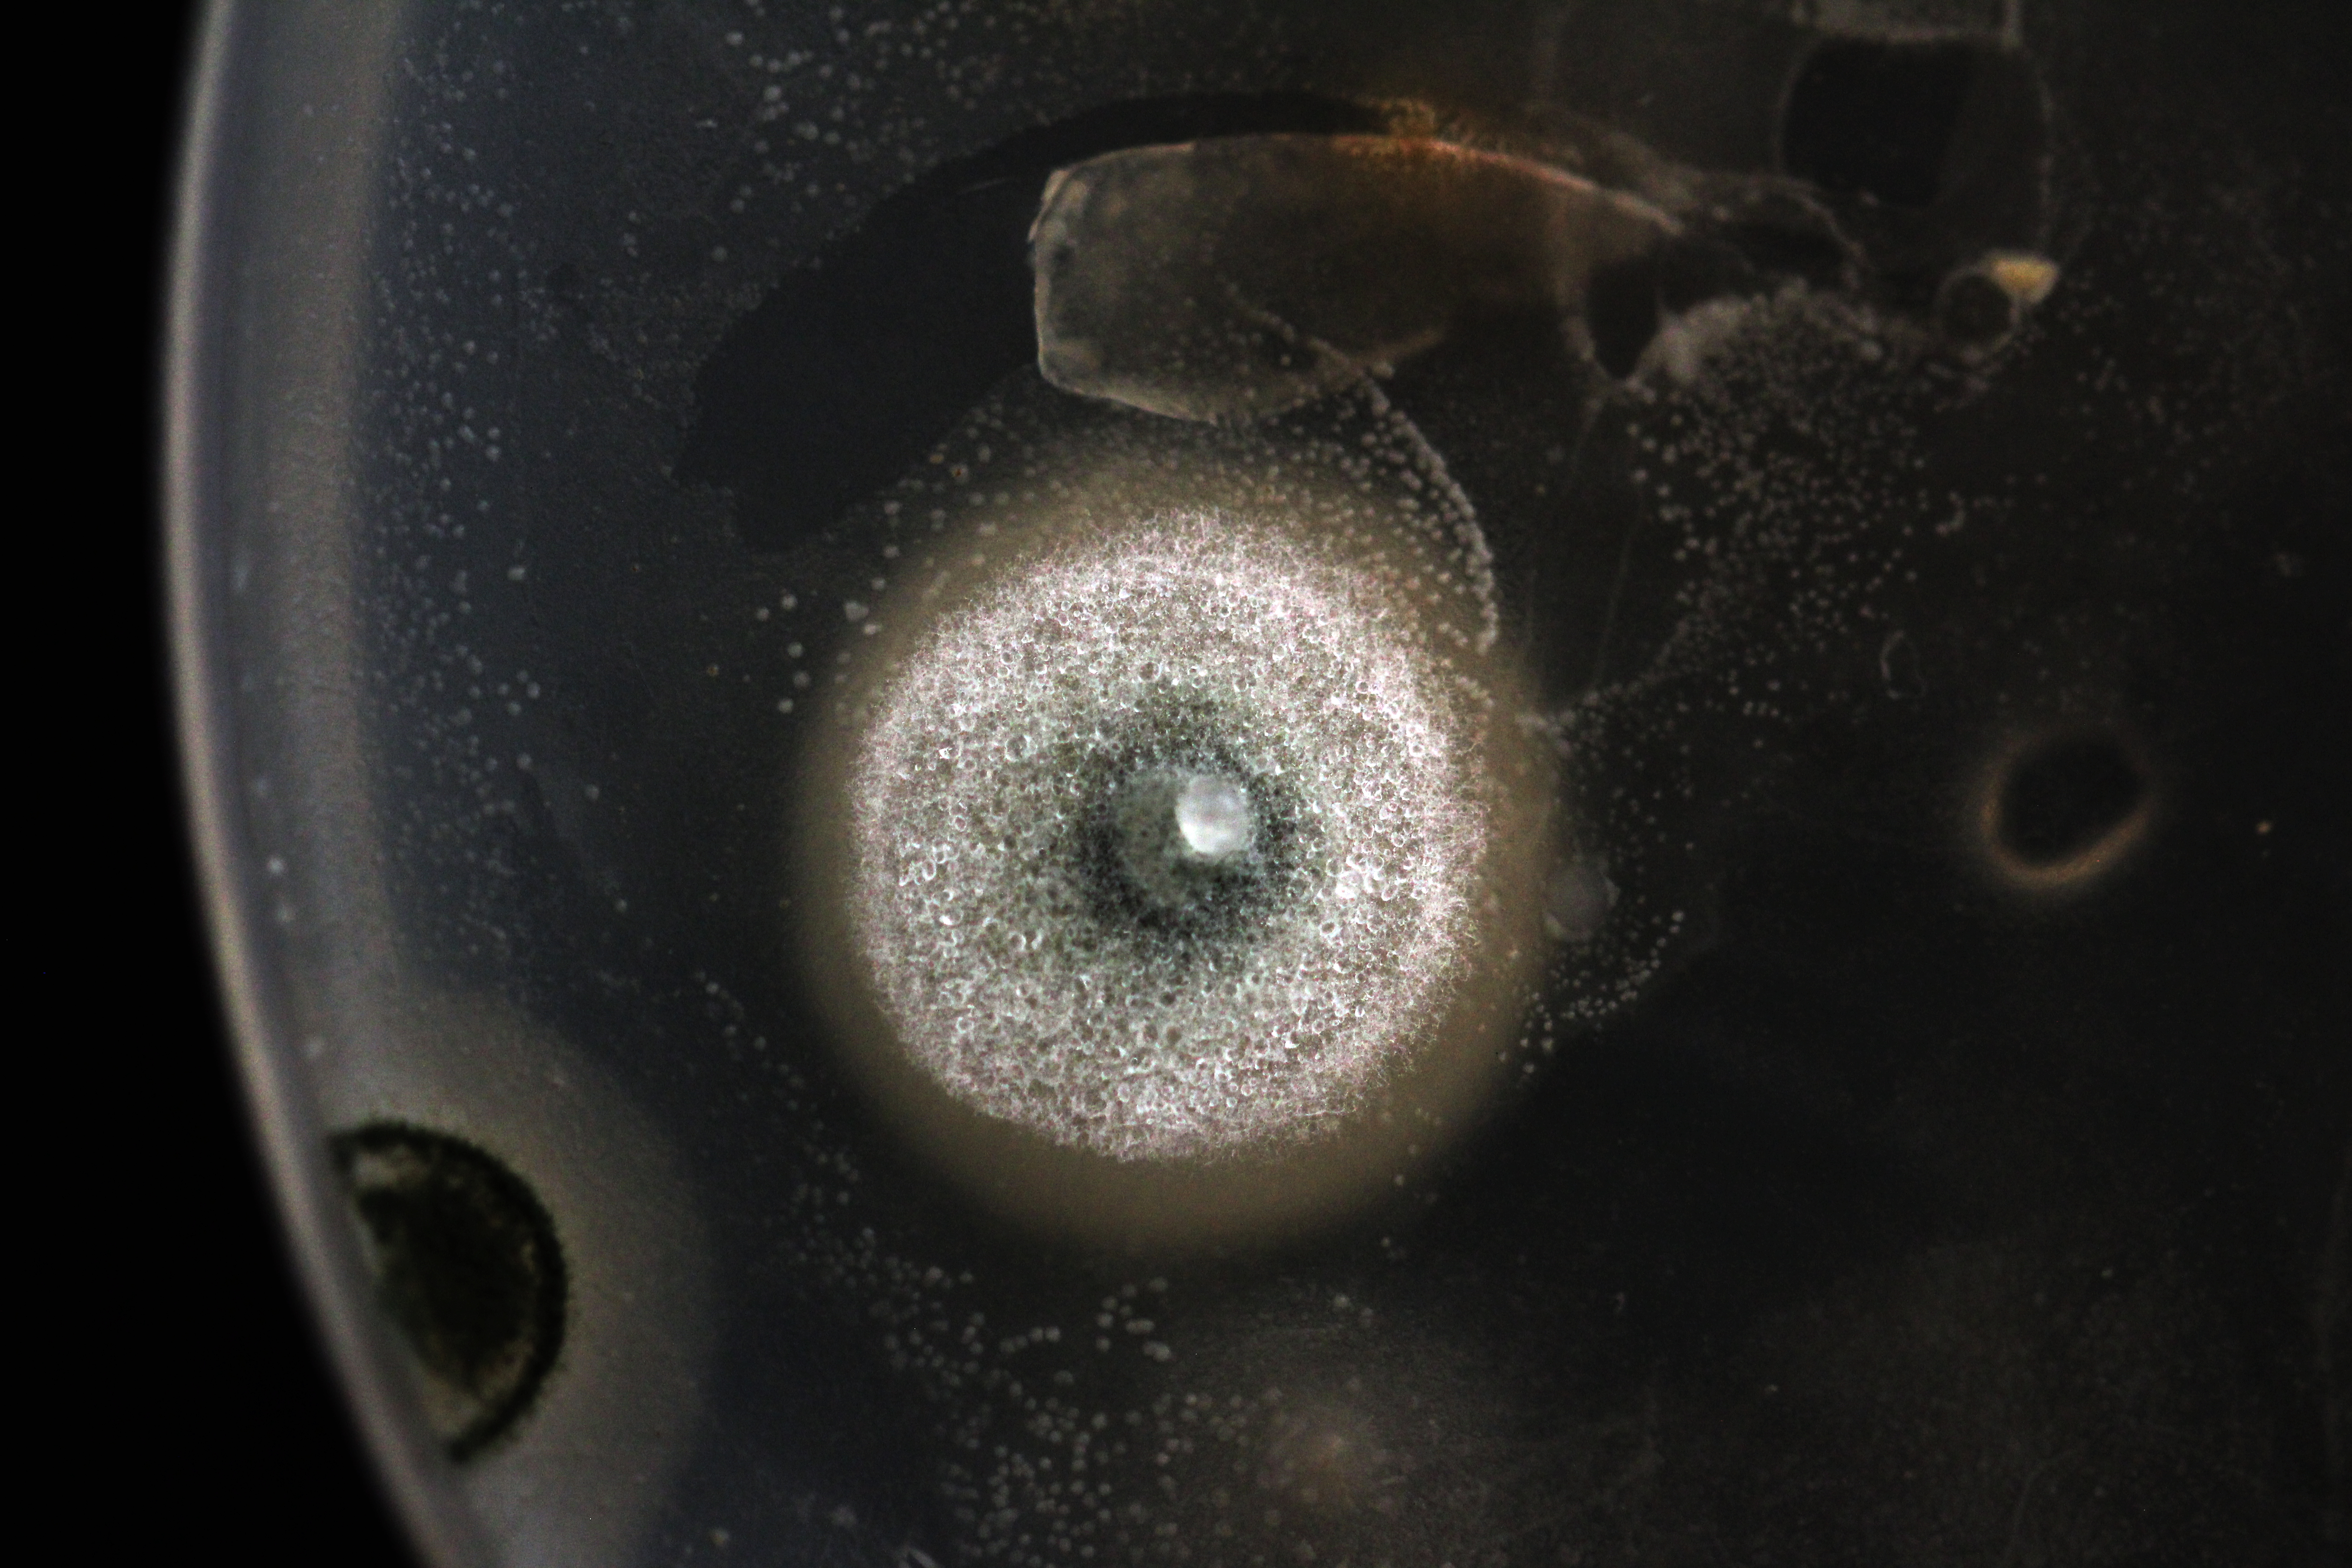

Christina Ly
"Impermanence - the quality or state of being ephemeral"
Keywords: water, bodies, pollution, photography
As bodies of water, we rely on water for our continued proliferation, but we are also reservoirs for this proliferating force of life-in-the-plural.” At the same time “…as an ‘ontologic’ of amniotics – a mode of embodiment that highlights water as that which both connects us and differentiates us; as that which we both are and which facilitates our becoming. 1
This project investigates the relationship between the human as a body of water and the primary source of London’s drinking water in London, the River Lea. Water and the human body are infused within one another: the human as a vessel and the hydrologic cycle of water above and below the earth’s surface. Most of us expect access to clean drinking water each time we turn on the faucet – we feel secure about our water. But do we know where the water comes from or where it goes?
The River Lea rises north of Luton, in Bedfordshire, England – flowing 46 miles east and then south to enter the River Thames in Bromley-by-Bow in the London borough of Tower Hamlets. Existing as one of the largest rivers in London and the easternmost major tributary of the Thames, the river remains one of London’s major sources of drinking water. However, it is also one of the most polluted rivers in the country, from raw sewage discharge to human misuse.
The Experiment, as I called it, consisted of collecting water samples containing river sediments or algae and weeds. The samples were pressed into self-made agar plates, incubated for up to a week, and photographed after bacteria growth had occurred. The resulting images reveal a portrait of the city’s complex water ecosystem that each of us contributes to and a visual analogy of us as a human body of water.
Neimanis, Astrida, Bodies of Water: Posthuman Feminist Phenomenology (Bloomsbury Publishing, 2017), p. 111. ↩